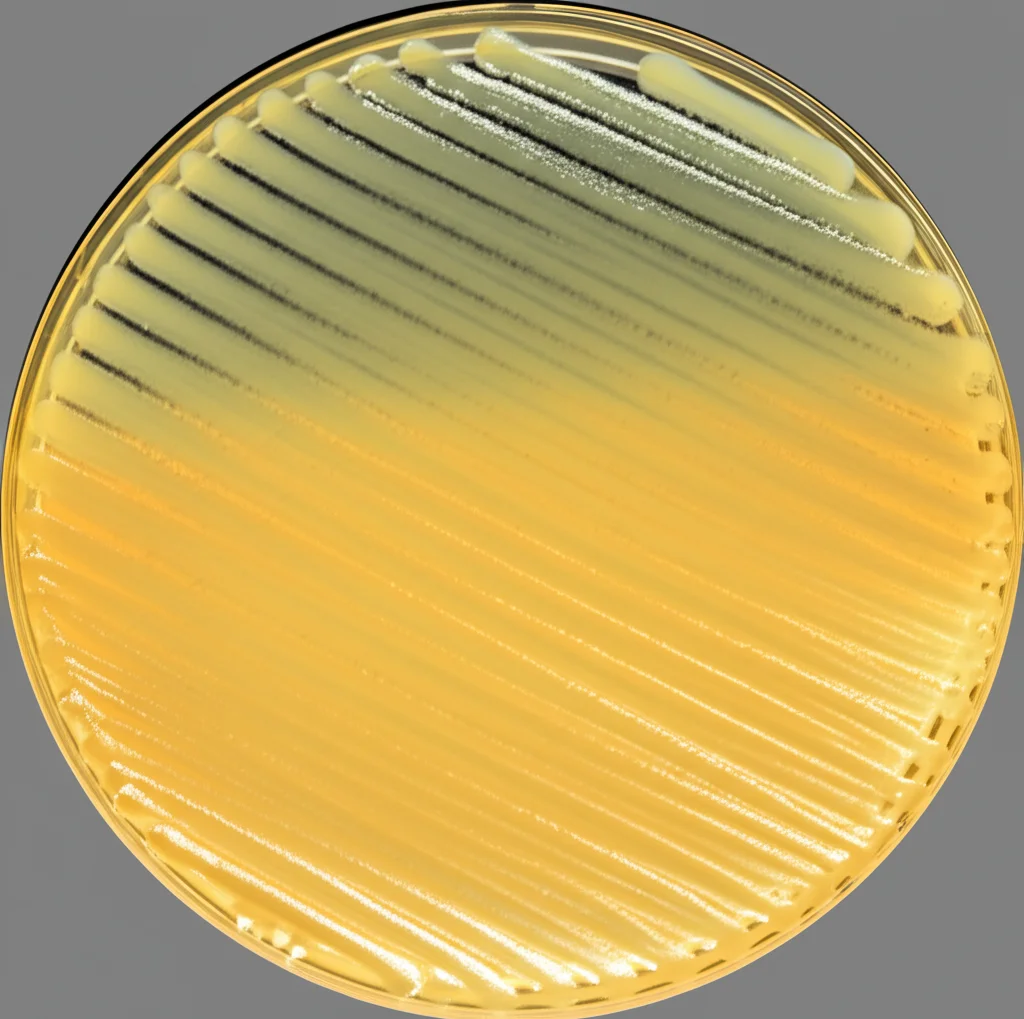
Colonie batteriche di Bacillus cereus su piastra Petri, fotografia macro 100mm, alta definizione, illuminazione controllata per evidenziare la morfologia filamentosa tipica di alcune specie di Bacillus.

Bacillus: Il Nuovo Nemico Nascosto che Minaccia le Nostre Api?
Ciao a tutti! Oggi voglio parlarvi di qualcosa che mi sta molto a cuore e che, scommetto, interessa anche voi: le api. Non solo per il miele delizioso che ci regalano, ma perché sono fondamentali per la vita sul nostro pianeta. Senza la loro impollinazione, addio a tantissima frutta e verdura! Purtroppo, come ben sappiamo, le nostre amiche ronzanti non se la passano benissimo. Tra pesticidi, cambiamenti climatici e malattie, la loro sopravvivenza è messa a dura prova.
Le Minacce Conosciute (e Quelle Nuove)
Quando si parla di malattie che colpiscono la “nursery” dell’alveare, cioè la covata (uova e larve), di solito saltano fuori due nomi spaventosi: la Peste Americana (AFB), causata dal batterio Paenibacillus larvae, e la Peste Europea (EFB), causata da Melissococcus plutonius. Sono nemici noti, capaci di decimare intere colonie. Ma se vi dicessi che c’è un nuovo “cattivo” in città, o meglio, nell’alveare, che finora era passato un po’ in sordina?
Recentemente, la nostra attenzione si è concentrata su una regione specifica, il Khyber Pakhtunkhwa (KPK) in Pakistan. Lì, l’apicoltura è un’attività importantissima, non solo per la produzione di miele pregiato come quello di Sidr, ma anche per l’impollinazione di colture essenziali. Eppure, anche lì le api soffrono, e le cause non sono sempre chiare.
L’Indagine: A Caccia di Batteri Sospetti
Così, ci siamo messi all’opera. Abbiamo deciso di andare a vedere più da vicino cosa succede nelle covate che mostravano segni di malattia in diversi distretti del KPK (Mardan, Nowshera, Charsadda, Swabi, Peshawar). Abbiamo raccolto campioni di favi con larve morte o scolorite, prelevando centinaia di piccole api in diverse fasi di sviluppo, dalle uova alle larve. L’idea era: ci sono altri batteri coinvolti oltre ai soliti noti?
Abbiamo portato questi campioni in laboratorio e abbiamo iniziato a “coltivare” i batteri presenti. Utilizzando tecniche biochimiche e molecolari (come l’analisi del DNA, in particolare del gene 16S rRNA, che è un po’ la carta d’identità dei batteri), abbiamo cercato di identificare chi fossero questi microbi.
La Sorpresa: Ecco i Bacillus!
E indovinate un po’? Abbiamo trovato un ospite inatteso, o meglio, una famiglia di batteri che è emersa come la più dominante nelle covate malate: i Bacillus. In particolare, due specie hanno attirato la nostra attenzione: Bacillus cereus e il suo parente stretto, Bacillus mycoides.
Ora, potreste pensare: “Bacillus? Mai sentito nominare in relazione alle api”. Ed è proprio questo il punto! Mentre B. cereus è più noto per causare intossicazioni alimentari nell’uomo, il suo ruolo nelle malattie delle api è stato finora poco esplorato, soprattutto in Pakistan. Eppure, i nostri risultati suggeriscono che potrebbe essere un attore importante.
Perché Preoccuparsi di Questi Bacillus?
Questi batteri non sono da sottovalutare. Ecco perché:
- Formano spore: Come il batterio della Peste Americana, anche i Bacillus possono formare spore resistentissime. Questo significa che possono sopravvivere a lungo nell’ambiente dell’alveare, resistendo a condizioni difficili e rendendo difficile l’eliminazione.
- Producono tossine: L’analisi molecolare ha rivelato che i ceppi di B. cereus isolati possiedono geni di virulenza chiave, come il gene cry, noto per le sue proprietà insetticide. Non solo, ma sono capaci di produrre citotossine, emolisine ed enterotossine. In parole povere, armi chimiche che possono danneggiare le cellule delle larve, indebolire il loro sistema immunitario e comprometterne la sopravvivenza.
- Potenziali opportunisti: Anche se forse non sono la causa primaria della malattia come P. larvae, questi Bacillus potrebbero agire come patogeni secondari o opportunisti. Immaginate una covata già indebolita da un virus o da stress ambientale: l’arrivo di B. cereus o B. mycoides potrebbe dare il colpo di grazia, peggiorando la situazione e portando alla morte delle larve.
- Disbiosi microbica: La presenza di B. mycoides, anche se la sua patogenicità diretta sulle api è ancora da chiarire, potrebbe contribuire a uno squilibrio nella comunità microbica dell’alveare (disbiosi), rendendo l’ambiente meno sano per le larve in via di sviluppo.
Cosa Abbiamo Osservato sul Campo (anzi, nell’Alveare)
Analizzando i dati raccolti nei diversi distretti del KPK, abbiamo notato che questi Bacillus erano piuttosto diffusi. Li abbiamo trovati in diverse specie di api campionate (Apis mellifera, l’ape europea comunemente allevata, Apis dorsata e Apis florea, specie selvatiche), anche se l’Apis cerana (un’altra specie nativa) sembrava non esserne colpita nei nostri campioni, forse per una maggiore resistenza o minore esposizione. L’ape Apis mellifera è risultata quella con la più alta frequenza di rilevamento, forse perché, essendo gestita dall’uomo, è più esposta a stress o alla circolazione di patogeni.
L’analisi filogenetica, che ricostruisce l’albero genealogico dei batteri basandosi sul loro DNA, ha confermato la stretta parentela tra le diverse specie di Bacillus isolate e B. cereus. Questo legame evolutivo è probabilmente dovuto alla loro comune capacità di formare spore, una strategia di sopravvivenza vincente che hanno affinato nel corso dell’evoluzione.

Un Campanello d’Allarme Globale
Questa scoperta in Pakistan non è un caso isolato. Segnalazioni simili che collegano queste specie di Bacillus al declino della salute delle api sono arrivate anche dal Nord America e dall’Europa. Questo ci dice che il problema potrebbe essere più diffuso di quanto pensassimo e che dobbiamo ampliare il nostro sguardo oltre i patogeni “classici”.
La presenza di B. cereus e B. mycoides suggerisce che l’ecologia microbica all’interno dell’alveare è incredibilmente complessa. Le malattie delle api potrebbero essere spesso il risultato di co-infezioni, dove diversi microbi (batteri, funghi, virus) interagiscono tra loro, magari potenziando a vicenda i loro effetti negativi. Fattori ambientali come l’esposizione ai pesticidi, i cambiamenti climatici e le pratiche di apicoltura intensiva potrebbero inoltre favorire la proliferazione di questi batteri opportunisti.
Cosa Fare Ora? La Ricerca Continua
Questo studio è solo l’inizio. È il primo report che documenta in modo specifico il coinvolgimento di queste specie di Bacillus nelle infezioni della covata in questa regione del Pakistan, gettando luce su una minaccia finora sottovalutata.
Ora è fondamentale approfondire:
- Capire i meccanismi: Come esattamente questi batteri danneggiano le larve? Quali tossine sono più rilevanti?
- Monitoraggio esteso: Dobbiamo ampliare la sorveglianza per includere un ventaglio più ampio di patogeni batterici, non solo in Pakistan ma ovunque.
- Interazioni microbiche: Studi più avanzati (come metagenomica e trascrittomica) possono aiutarci a capire come i Bacillus interagiscono con gli altri microbi presenti nell’alveare e nell’intestino delle api.
- Strategie di mitigazione: Potremmo esplorare l’uso di probiotici? Alcune ricerche suggeriscono che rafforzare il microbiota “buono” delle api potrebbe renderle più resistenti alle infezioni.

In conclusione, abbiamo identificato un potenziale nuovo nemico per le nostre preziose api nella forma dei batteri del genere Bacillus, in particolare B. cereus e B. mycoides. La loro capacità di produrre tossine e formare spore resistenti li rende una minaccia concreta per la salute della covata, specialmente in contesti già stressati. È un’ulteriore prova di quanto sia complesso e delicato l’ecosistema dell’alveare e di quanto sia urgente continuare a studiare e proteggere questi insetti fondamentali. Teniamo gli occhi aperti su questi Bacillus, perché capire il nemico è il primo passo per combatterlo!
Fonte: Springer
